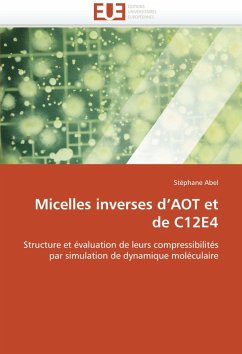

A comparison of molecular changes in casein micelles
of buffalo and cow milk under different physico-chemical conditions
Versandkostenfrei!
Versandfertig in 6-10 Tagen
52,99 €
inkl. MwSt.

PAYBACK Punkte
26 °P sammeln!
Buffalo milk is the second most produced milk in the world after cow milk with ~13% contribution in the world s milk production. Buffalo milk is generally richer in fat, lactose, minerals and protein particularly in casein contents than cow milk. Casein micelles play a key role in milk for its biological and technological functionalities. Despite of lot of literature on casein micelles of cow milk, its micellar organization and dynamics are not well known whereas the knowledge on casein micelles of buffalo milk is even far less especially in its native state and under different physico-chemica...
Buffalo milk is the second most produced milk in the world after cow milk with ~13% contribution in the world s milk production. Buffalo milk is generally richer in fat, lactose, minerals and protein particularly in casein contents than cow milk. Casein micelles play a key role in milk for its biological and technological functionalities. Despite of lot of literature on casein micelles of cow milk, its micellar organization and dynamics are not well known whereas the knowledge on casein micelles of buffalo milk is even far less especially in its native state and under different physico-chemical conditions. The objective of the thesis was to gain knowledge on casein micelle of buffalo milk and its molecular changes as a function of different physico-chemical conditions (ionic strengths, acidifications, alkalinisations and heat treatments). The comparison with casein micelles of cow milk was used as a reference throughout the study. Biochemical, physico-chemical, molecular, microscopic, macroscopic, physical and organoleptic approaches were used to compare casein micelles of both milks.